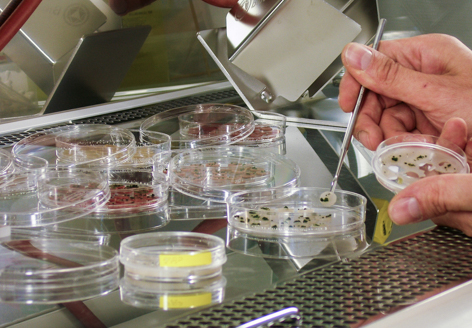
Προετοιμασία φυκών για τα πειράματα έξω από τον Διεθνή Διαστημικό Σταθμό. Photo Thomas Leya / Fraunhofer IZI-BB

Εστάλησαν στον Διεθνή Διαστημικό Σταθμό και έμειναν εκεί έξω, εκτεθειμένα στις συνθήκες του Διαστήματος. Υστερα από ενάμιση χρόνο όχι μόνο είχαν επιζήσει, αλλά επέστρεψαν σώα και αβλαβή, και συνεχίζουν ξανά κανονικά τη ζωή τους στη Γη
Προετοιμασία φυκών για τα πειράματα έξω από τον Διεθνή Διαστημικό Σταθμό.
Photo Thomas Leya / Fraunhofer IZI-BB
Πριν από περίπου δύο χρόνια φύκη από τον παγωμένο Αρκτικό κύκλο ξεκίνησαν μαζί με μερικούς ακόμη πρωτόγονους γήινους οργανισμούς για ένα παράξενο ταξίδι. Εστάλησαν στον Διεθνή Διαστημικό Σταθμό (ISS) και «κρεμάστηκαν» με ειδικά πάνελ σε ένα εξωτερικό τμήμα του, εκτεθειμένα στις συνθήκες που επικρατούν στο Διάστημα, έξω από την τροχιά της Γης. Οι διαστημικοί ταξιδιώτες επέστρεψαν πρόσφατα στη βάση τους σώοι και αβλαβείς και φαίνονται να χαίρουν άκρας υγείας, προς μεγάλη έκπληξη αλλά και χαρά των επιστημόνων που διοργάνωσαν την αποστολή. Οπως ανακοινώθηκε, τα φύκη όχι μόνο επέζησαν στο σκληρό διαστημικό περιβάλλον αλλά, σύμφωνα με τα μέχρι τώρα αποτελέσματα, φαίνονται να συνεχίζουν φυσιολογικά τη ζωή τους από τη στιγμή που βρέθηκαν ξανά στον πλανήτη μας. Κατόπιν αυτού η συζήτηση γύρω από τη θεωρία της πανσπερμίας, η οποία θέλει τη ζωή να έφθασε στη Γη από κάποια άλλη γωνιά του Σύμπαντος με «όχημα» κάποιον μετεωρίτη, έρχεται ξανά στο προσκήνιο, καθώς τα ευρήματα της προσθέτουν έναν ακόμη «πόντο».
Πράσινα, πορτοκαλί και μπλε
Τα «φύκη του ISS», όπως τείνουν πλέον να μείνουν γνωστά, είναι άκρως εξωτικά και για τα γήινα δεδομένα, καθώς πρόκειται για πανάρχαιους οργανισμούς οι οποίοι ζουν στο μόνιμα παγωμένο έδαφος των πολικών περιοχών. Το ένα είδος ανακαλύφθηκε πρόσφατα στο αρχιπέλαγος Σβάλμπαρντ της Νορβηγίας από τον Τόμας Λάια του Ινστιτούτου Φραουνχόφερ Κυτταρικής Θεραπείας και Ανοσολογίας στο Πότσδαμ της Γερμανίας. Οπως εξηγεί ο βιολόγος στο «Βήμα», ανήκει στις σφαιροκύστεις και ακόμη δεν έχει καν περιγραφεί ταξινομικά: προς το παρόν τα φύκη αυτά είναι γνωστά με τον κωδικό CCCryo 101-99. Ωστόσο τα επέλεξε για το συγκεκριμένο πείραμα ακριβώς επειδή είναι προσαρμοσμένα να επιβιώνουν σε τόσο ακραίες συνθήκες. Στον δριμύ και ξηρό αρκτικό χειμώνα ή και κατά περιόδους το καλοκαίρι, όταν δεν υπάρχει νερό, τα CCCryo 101-99 «κατεβάζουν» τον μεταβολισμό τους, αφυδατώνονται και σκληραίνουν ενώ από πράσινα γίνονται πορτοκαλί, συνθέτοντας υψηλές ποσότητες καροτενοειδών για να προστατευθούν από την ακτινοβολία – θα μπορούσε να πει κάποιος ότι είναι σαν να πέφτουν σε νάρκη. Οταν αρχίζουν οι βροχές, τα CCCryo 101-99 «ξυπνούν», ανεβάζουν τον μεταβολισμό τους στους φυσιολογικούς ρυθμούς και γίνονται πάλι πράσινα, αρχίζοντας ξανά να φωτοσυνθέτουν και να αναπτύσσονται. Μαζί με τα πράσινα αρκτικά φύκη ο κ. Λάια έστειλε στον ISS και ένα ακόμη αρχαιότερο είδος από την Ανταρκτική: ανήκει στα λεγόμενα «κυανοφύκη», αλλά στην ουσία πρόκειται για ένα κυανοβακτήριο το οποίο αποτελεί έναν από τους πρώτους οργανισμούς που άρχισαν να παράγουν οξυγόνο στη Γη.
Τροφή για την πανσπερμία
Σημαίνει αυτό ότι αν δεν έχει προστασία από την υπεριώδη ακτινοβολία ένας οργανισμός δεν μπορεί να επιβιώσει ταξιδεύοντας στο Διάστημα επάνω σε έναν μετεωρίτη; «Οι συγκεκριμένοι οργανισμοί όχι, δεν θα μπορούσαν» απαντά ο δρ Λάια. «Από την άλλη πλευρά, αν αναφέρεστε στη θεωρία της πανσπερμίας, αυτή θέτει το ερώτημα: Είναι πιθανό κάποιο βιομόριο, μια αρχική μορφή ζωής, να επιζήσει επάνω σε έναν μετεωρίτη; Αν φανταστείτε έναν μετεωρίτη με τις τόσες σχισμές και τα σκιασμένα σημεία, ένα οργανικό μόριο θα μπορούσε να κρυφτεί σε αυτές τις σχισμές και τότε θα ήταν προστατευμένο από την ακτινοβολία. Η UV A, B, και C είναι πολύ βλαβερή, αλλά μπορεί κάποιος να προστατευθεί αν καλυφθεί ή κρυφτεί από αυτήν». Και υπογραμμίζει: «Το πείραμά μας δεν αποδεικνύει ότι η θεωρία της πανσπερμίας είναι σωστή, προσφέρει όμως πληροφορίες που δεν είχαμε ως τώρα. Δείχνει ότι εν γένει οι οργανισμοί μπορούν να επιβιώσουν στο διαστημικό κενό και στις θερμοκρασίες, καθώς και σε έναν βαθμό υπεριώδους ακτινοβολίας. Μόνο αυτά μπορούμε να πούμε. Αλλά αυτό είναι περισσότερα από όσα γνωρίζαμε ως τώρα».
Και πράγματι, τα «κοιμισμένα» πράσινα και μπλε φύκη επιβίωσαν επί σχεδόν ενάμιση χρόνο, ώσπου να επανέλθουν στη Γη. «Επέζησαν όλα τα δείγματα, εκτός από ένα, αλλά δεν ξέρουμε ακόμη για ποιον λόγο αυτό δεν έζησε» λέει ο κ. Λάια. Στο επόμενο στάδιο του πειράματος, το οποίο αποτελεί μέρος του ευρύτερου Biology and Mars Experiment (BIOMEX) με επικεφαλής τον Ζαν-Πιερ ντε Βέρα από το Γερμανικό Αεροδιαστημικό Κέντρο (DLR), ερευνητές από το Πολυτεχνείο του Βερολίνου, το DLR και την κλινική Mayo στις ΗΠΑ θα αναλύσουν το DNA των φυκών του ISS για να διαπιστώσουν αν έχει υποστεί μεταλλάξεις. «Εγώ έκανα καλλιέργειες με τα δείγματα από τον ISS στο εργαστήριό μου» λέει ο κ. Λάια. «Τους έβαλα νερό και θρεπτικά συστατικά και παρήγαγαν μικρά πράσινα κύτταρα όπως είχα δει ότι κάνουν τα δείγματα ελέγχου που δεν βγήκαν ποτέ στο Διάστημα. Φαίνονται ακριβώς τα ίδια, πολλαπλασιάζονται κανονικά, επίσης συνθέτουν καροτενοειδή. Εκ πρώτης όψεως φαίνονται φυσιολογικά. Μπορεί όμως να ανακαλύψουμε κάποια μετάλλαξη, π.χ. σε κάποιο ένζυμο».
Κύριος στόχος των μελετών αυτών, όπως τονίζει ο βιολόγος, είναι να εξαχθούν πληροφορίες σχετικά με τον ισχυρό μηχανισμό προστασίας από την υπεριώδη ακτινοβολία που φαίνεται να διαθέτουν τα αρκτικά φύκη. «Εχουν αυτή την άμυνα επειδή βρίσκονται σε κατάσταση νάρκης ή μήπως συνθέτουν κάποιες πρωτεΐνες; Δεν ξέρουμε ακόμη, όπως σας προανέφερα γνωρίζουμε ακόμη πολύ λίγα για αυτά τα φύκη, αν όμως συμβαίνει το δεύτερο θα μπορούσαν να αποτελέσουν τη βάση για την ανάπτυξη αποτελεσματικών αντηλιακών προϊόντων και καλλυντικών».
Φαφούτη Λαλίνα, tovima.gr – www.fraunhofer.de
Κατηγορίες:ΔΙΑΣΤΗΜΑ, ΔΙΑΣΤΗΜΙΚΟΣ ΣΤΑΘΜΟΣ
Σχολιάστε